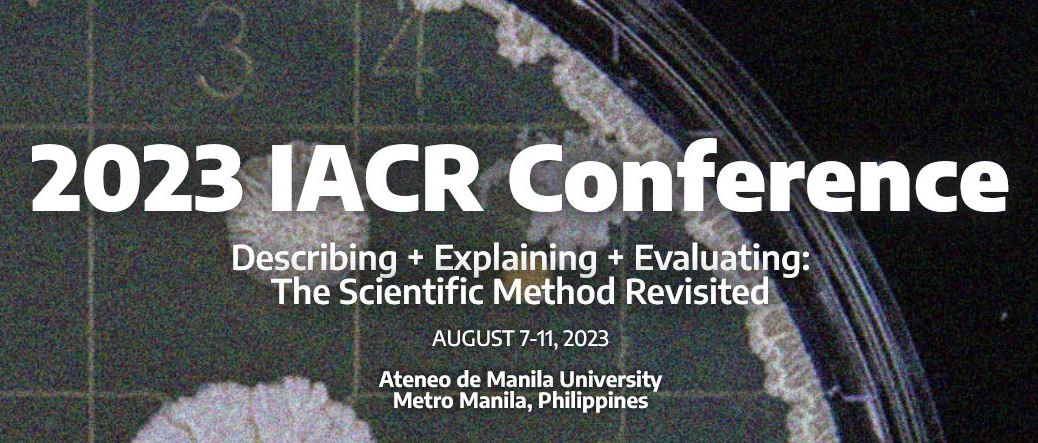

The 2023 Annual Conference of the International Association for Critical Realism (IACR) will take place from the 9th to the 11th of August 2023 (+ pre-conference on the 7th and the 8th of August 2023). It will be hosted by the Gokongwei Brothers School of Education and Learning Design (GBSEALD) of the Ateneo de Manila University. All details of the event – including themes, call for papers, plenary speakers, submission timeline and transportation & accommodation information – can be found on the conference website here.